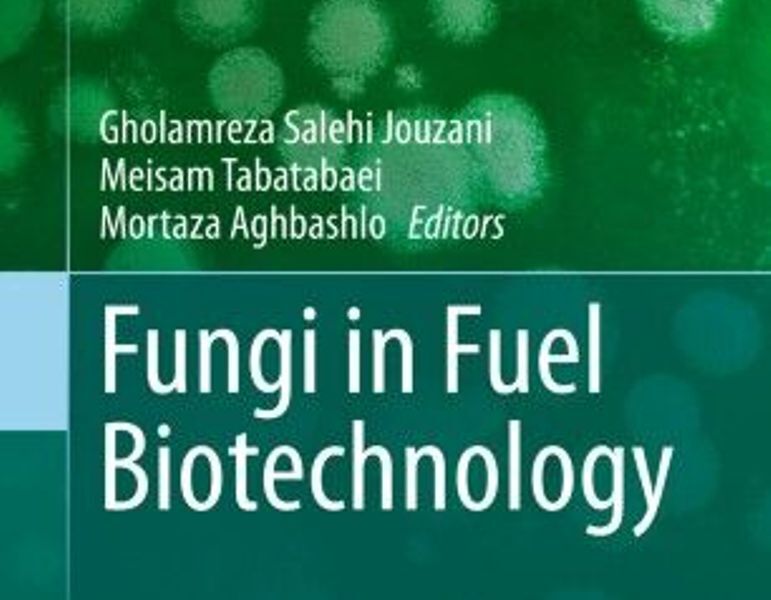

ID :
586559
Wed, 12/30/2020 - 23:57
Auther :
Shortlink :
http://m.oananews.org//node/586559
The shortlink copeid
Iranian book of "Fungi in Fuel Biotechnology" published
Karaj, Dec 30, IRNA – The book "Fungi in Fuel Biotechnology" was published by the faculty members of the Iranian Agricultural Biotechnology Research Institute by the prestigious International Springer Publications.
The book was written by Gholamreza Salehi Jouzani, Meisam Tabatabaei, and Mortaza Aghbashlo.
Reviewing the types of biofuels and barriers to their production, the potentials of fungi and yeasts in the production of biofuels (bioethanol and biodiesel) from different dimensions have been discussed in the book.